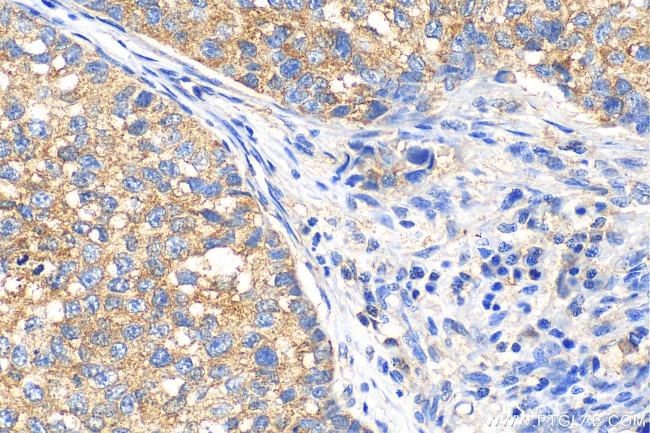
Fibroblast activation protein alpha Antibody in Immunohistochemistry (Paraffin) (IHC (P))

Search
Proteintech
Fibroblast activation protein alpha Polyclonal Antibody
{{$productOrderCtrl.translations['antibody.pdp.commerceCard.promotion.promotions']}}
{{$productOrderCtrl.translations['antibody.pdp.commerceCard.promotion.viewpromo']}}
{{$productOrderCtrl.translations['antibody.pdp.commerceCard.promotion.promocode']}}: {{promo.promoCode}} {{promo.promoTitle}} {{promo.promoDescription}}. {{$productOrderCtrl.translations['antibody.pdp.commerceCard.promotion.learnmore']}}
图: 1 / 4
Fibroblast activation protein alpha Antibody (27596-1-AP) in IHC (P)




产品信息
27596-1-AP
种属反应
宿主/亚型
分类
类型
抗原
偶联物
形式
浓度
规格
纯化类型
保存液
内含物
保存条件
运输条件
产品详细信息
Immunogen sequence: VVRIFIIDTT YPAYVGPQEV PVPAMIASSD YYFSWLTWVT DERVCLQWLK RVQNVSVLSI CDFREDWQTW DCPKTQEHIE ESRTGWAGGF FVSTPVFSYD AISYYKIFSD KDGYKHIHYI KDTVENAIQI TSGKWEAINI FRVTQDSLFY SSNEFEEYPG RRNIYRISIG SYPPSKKCVT CHLRK
靶标信息
The protein encoded by this gene is a homodimeric integral membrane gelatinase belonging to the serine protease family. It is selectively expressed in reactive stromal fibroblasts of epithelial cancers, granulation tissue of healing wounds, and malignant cells of bone and soft tissue sarcomas. This protein is thought to be involved in the control of fibroblast growth or epithelial-mesenchymal interactions during development, tissue repair, and epithelial carcinogenesis.
仅用于科研。不用于诊断过程。未经明确授权不得转售。
篇参考文献 (0)
生物信息学
蛋白别名: 170 kDa melanoma membrane-bound gelatinase; Dipeptidyl peptidase FAP; FAPalpha; Fibroblast activation protein alpha; Gelatine degradation protease FAP; Integral membrane serine protease; Post-proline cleaving enzyme; Prolyl endopeptidase FAP; Seprase; Serine integral membrane protease; SIMP; Surface-expressed protease; unnamed protein product
基因别名: DPPIV; FAP; FAPA; FAPalpha; SIMP
UniProt ID: (Human) Q12884, (Mouse) P97321
Entrez Gene ID: (Human) 2191, (Mouse) 14089